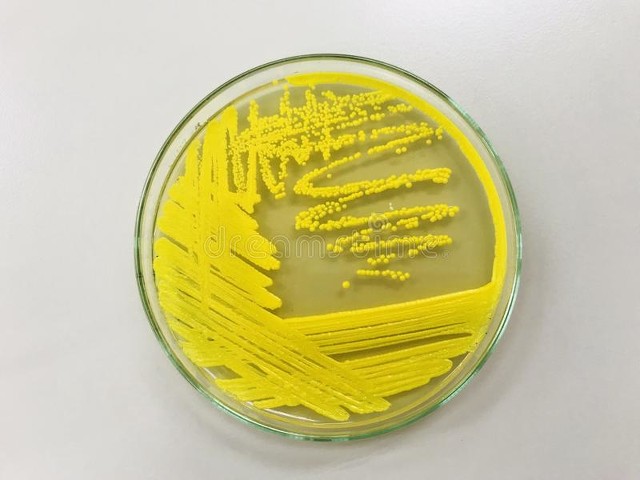
海鲜的药理作用和毒性

鲎hou

鲘
这种节肢动物的血液中充满了变形细胞,这些细胞会对微量细菌产生反应。在过去的50年中,它们的血液已被用于检测设备和疫苗的污染情况。
芋螺

芋螺
这种软体动物的刺含有芋螺毒素。研究人员基于该毒素已经研发出了一种比*啡吗**更有效的止痛药。治疗癌症和糖尿病的药物也将有望被研发出来。
多刺海星

海星
这种海星的身体被黏液覆盖着,黏液中包含14%的碳水化合物和86%的蛋白质。目前研究人员正在研究运用该物质治疗关节炎和哮喘。
河豚

这种鱼含有河鲀毒素,这正是由河鲀制成的美味佳肴会成为致命晚餐的原因。目前研究人员正在研究用河鲀毒素来缓解病人在化疗期间的疼痛。
藤黄微球菌
这种细菌会产生一种叫作八叠球菌黄素的色素,可以阻挡长波的紫外线辐射。科学家正在研究如何将其用于开发更有效的防晒霜。
南极海绵

这种海绵含有一种叫海绵状二萜的物质。该物质可以有效地对抗有很强耐药性的超级细菌——耐甲氧西林金黄色葡萄球菌,这种细菌经常会在医院引发疾病。
橙缘白斑海天牛

这种海天牛分布广泛,它含有一种叫作KF的有毒多肽物质。目前研究人员正把它作为潜在的抗肿瘤药物进行研究。